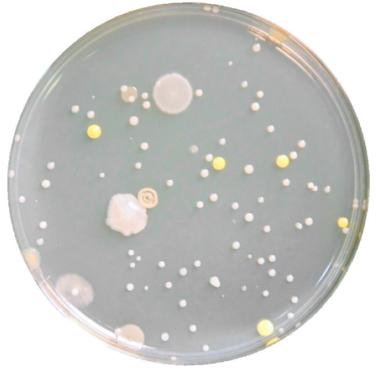

En vente dans les grandes filiales Migros, chez melectronics et en ligne sur delizio.ch. Les articles déjà réduits sont exclus de toutes les offres. Offre valable uniquement du 7.3 au 13.3.2023, jusqu’à épuisement du stock.



































En vente dans les grandes filiales Migros, chez melectronics et en ligne sur delizio.ch. Les articles déjà réduits sont exclus de toutes les offres. Offre valable uniquement du 7.3 au 13.3.2023, jusqu’à épuisement du stock.


































8.95 Set de marqueurs de contour métalliques



8 pièces, le set
37%
5.95 Set de tampons en bois le set


Les articles bénéficiant déjà d’une réduction sont exclus de toutes les offres. Offres valables du 7.3 au 13.3.2023 ou jusqu’à épuisement du stock.

15.95
au lieu de 25.35
3.95 Pinces à linge en bois Folia pastel, 48 pièces


Petits œufs en chocolat Classics, Freylini Frey en emballage spécial, le sachet de 1,3 kg

Carottes, radis, chicorée frisée: la salade Alice a tout de la merveille.
Une cuisine rapide et savoureuse? Anna (’s Best) est la meilleure pour cela.
Le chocolat Tourist ne plaît pas qu’aux visiteurs de passage. Les Suisses l’aiment aussi, notamment en version «Blanca».
Merci à Heidi, toujours prête à apporter aux citadins des produits laitiers et des spécialités provenant des régions de montagne suisses.
Le siège poire Lotta de Micasa aime tout le monde, quel que soit sa taille ou son poids.
Marie (Croccant), ce biscuit sablé enrichi d’une nougatine de noisettes, a tout du péché véniel.
Difficile de dire non aux crèmes glacées Mary Jane’s, qui ont tout du dessert réconfortant. Mary Jane’s Almost Cookie, 450 ml, Fr. 4.50

Xenia est certes aussi une guerrière et un modèle de voiture, mais c’est surtout une feta AOP qui séduit les palais.
Il n’y a pas une mais des «Yvette» à Migros, une grande famille de lessives pour tous les types de vêtements.
Pour un visage éclatant, les cosmétiques Zoé donnent volontiers un coup de main.
S’il ne fallait lire qu’un seul livre en ce début d’année, c’est peut-être celui-ci: La brillante destinée d’Elizabeth Zott L’auteure, Bonnie Garmus, y narre le parcours d’une chimiste, Elizabeth Zott donc, qui évolue dans un monde d’hommes dans les années 1960 aux États-Unis. Confrontée à un monde conservateur, elle deviendra présentatrice d’une émission culinaire, où elle incitera les femmes à suivre leur propre voie plutôt que de tester de nouvelles recettes. Un livre drôle et profond, un personnage attachant, un best-seller international. En vente sur exlibris.ch

Avec ses articles sur la science, la psychologie, la société et l’environnement, le magazine Kaleio encourage les filles âgées de 8 à 13 ans (et tous les autres adolescents) à développer leurs connaissances et trouver leur propre chemin dans la vie – le tout sans clichés genrés et avec humour. Paraissant tous les deux mois, Kaleio bénéficie du soutien du Pour-cent culturel Migros. La revue peut être commandée sur https://kaleiomag.ch/fr

Bâtonnets aux noisettes Sélection

58,5
En 2022, le groupe Migros employait 58,5% de femmes. C’est dans le secteur des voyages que la proportion est la plus élevée (67,8%).
Réponse: B. Une rose a été créée en l’honneur de l’épouse de Gottlieb Duttweiler. Elle sera à nouveau en vente dans les Do it + Garden Migros dès le 2 mai. Concernant les -bâton nets aux noisettes, la recette vient bel et bien d’Adele Duttweiler mais ils ne portent pas son nom.


Au Bénin, le karité est récolté et transformé en beurre avant tout par des femmes. Or, la production est pénible et les rendements faibles. Soutenue par le Fonds de soutien Migros, l’association Pont – Die Brücke leur vient en aide afin d’améliorer le processus de production, d’augmenter la qualité des produits et d’accroître la rentabilité. Ce projet, qui offre un complément précieux aux revenus des familles, favorise aussi l’indépendance des femmes. migros-engagement.ch/le-pont
La plateforme Migros Forum elle s’engage depuis 1957 pour l’échange et le réseautage entre femmes. Il existe aujourd’hui seize sections dans tout le pays, ouvertes à toutes. forum-elle.ch

Le moment Migros La Mini-Migros mobile sillonne à nouveau la Suisse. Elle invite les enfants à jouer au supermarché sur une surface de plus de 100 m2, comme ici à St. Margrethen (SG). La première escale en Suisse romande se fera à Genève, à Balexert, le 22 mai. On peut consulter les dates des autres étapes sur www.migmag.ch/mini-migros.








20x
Les articles bénéficiant déjà d’une réduction sont exclus de toutes les offres. Offres valables du 7.3 au 20.3.2023, jusqu’à épuisement du stock.






 3.80 Blévita Hot & Smoky Paprika 228 g
20x CUMULUS Nouveau
3.95 Blévita Lemon & Pepper 228 g
CUMULUS Nouveau
3.80 Blévita Hot & Smoky Paprika 228 g
20x CUMULUS Nouveau
3.95 Blévita Lemon & Pepper 228 g
CUMULUS Nouveau
Recevez chaque dimanche notre newsletter et découvrez de nombreux conseils pratiques.

Trop de professions sont encore genrées. Forte de ce constat, Andrea Delannoy s’est donné pour mission de casser les stéréotypes de genre qui limitent le choix de la carrière chez les jeunes. Et pour elle, la lutte commence à l’école.
Page 12
20%
TOUTES LES TARTELETTES DE PÂQUES EN LOT DE 2 ET LES GÂTEAUX DE PÂQUES p. ex. tartelettes de Pâques, 2 pièces, 150 g, Fr. 2.25 au lieu de Fr. 2.85, emballées.

Vous trouverez d’autres actions et nouveautés dans le supplément encarté.
10 8 mars
Quel est le profil type de la femme qui habite en Suisse?

16 Génération
La colocation réussie entre une octogénaire et une étudiante.
20 Finances
Comment économiser des impôts sur sa propriété?
27 Saveurs
Les meilleures recettes à l’ail des ours.
33 Votre région
Votre coopérative Migros.
41 Science
Les applications de la biologie de synthèse dans l’écologie et la santé.
44 Maison
Comment maintenir un taux d’humidité idéal dans son logement.
49 Concours
54 Métier
Sabrina Bénézet, sur la réalité de la profession de détective privée.
À l’occasion de la Journée internationale des femmes, nous nous sommes demandé quel était le profil type de la femme résidant en Suisse, sur la base de données statistiques.


Texte: Thomas Piffaretti
VIE PRIVÉE
CARTE D’IDENTITÉ ÂGE 47,5 ans. C’est l’âge moyen de la Suissesse.
ORIGINE 75% sont originaires de Suisse*.
DOMICILE 62,5% sont domiciliées en ville.
RELIGION 20% sont catholiques.
LANGUE 56,2% parlent suisse allemand à la maison.
PART DE LA POPULATION 50,4%
* Ce chiffre inclut les doubles nationalités
FORMATION ET EMPLOI
ÉTUDES 42,2% ont fait des études supérieures.
SALAIRE 6211
francs en moyenne pour un plein temps, en progression de 11,5% en 10 ans.
TAUX D’ACTIVITÉ
62,2%
DOMAINE D’ACTIVITÉ 25,9%
sont employées de bureau.
HIÉRARCHIE 35,6% occupent des fonctions de cadres.
RENTE AVS
1886
francs en moyenne par mois.
ÉTAT CIVIL 76% des femmes en Suisse sont en couple. Parmi elles, 41% sont mariées.
MARIAGE
30,3 ans. C’est l’âge moyen auquel les Suissesses se marient pour la première fois.
D IVORCE
15,7 ans. C’est la durée moyenne du mariage pour les femmes qui divorcent.
ENFANT

1,5
C’est le nombre moyen d’enfants par femme.
MÉNAG E 30,2 heures par semaine. C’est le temps consacré aux tâches ménagères par les femmes.
SANTÉ
ESPÉRANCE DE VIE
85,7 ans.
CAUSE DE MORTALITÉ
28,6% décèdent de maladies cardiovasculaires.
CIGARETTE
42,1% sont fumeuses.
LOISIRS ET MOBILITÉ
SPORT
63,7%
pratiquent une activité physique de manière intensive au moins une fois par semaine.
ENGAGEMENT
26,3% sont impliquées dans une activité bénévole associative.
VOITURE
75,6% ont le permis de conduire.
TRANSPORTS PUBLICS
61,3% ont un abonnement.
Éléonore Lépinard, professeure associée au Centre en études genre de la Faculté des sciences sociales et politiques de l’Université de Lausanne.

Quelles réflexions vous inspire ce portrait de la femme suisse?

Il raconte une histoire qui est celle des pays européens actuels: une population qui vieillit, un taux de natalité relativement faible, une population qui vit de plus en plus dans les centres urbains, qui a des origines immigrées et qui est de plus en plus éduquée. Ce portrait nous parle aussi en filigrane des inégalités: par exemple la répartition des tâches domestiques (ndlr: 19,3 heures pour les hommes) et les salaires (ndlr: 6963.– pour les hommes).
Vous semble-t-il conforme à la réalité?
Tout portrait «moyen» tend à gommer des inégalités selon le genre, les origines sociales, les cantons où on vit. Il permet de dégager de grandes tendances mais rend invisibles d’autres processus bien enracinés. Par exemple, ici, on ne sait rien des femmes d’origine immigrées et de leur situation. Dans quelle mesure la nationalité suisse donnet-elle accès à de meilleurs salaires, une meilleure éducation ou de meilleures perspectives de rente?


Quels sont les domaines où la société suisse doit encore progresser?
La prise en charge de la petite enfance est le point noir du bilan suisse. Sur la question de l’égalité salariale, la politique plus volontariste du Conseil fédéral a permis de mettre le sujet sur la table et de proposer aux employeurs des outils de contrôle, c’est un bon début même si les résultats se font encore attendre! MM
«Tout portrait moyen tend à gommer des inégalités»Sources: ces chiffres ont été récoltés auprès des différentes bases de données de l’Office fédéral de la statistique (OFS).

Beaucoup de professions restent encore des bastions masculins ou féminins.
L’économiste Andrea Delannoy, qui combat les stéréotypes de genre à travers son association Mod-Elle à Lausanne, tente d’expliquer pourquoi.
Texte: Patricia Brambilla
Andrea Delannoy, seuls 17% des métiers seraient mixtes. En 2023, les métiers ont-ils toujours un genre?
Ils ne devraient pas en avoir un. Mais, bien que les écarts de formation entre les femmes et les hommes aient quasi disparu, les choix de filières d’études, puis de professions, demeurent sexués. Les métiers du «care» (santé, enseignement, travail social) restent très féminisés et les métiers MINT (mathématiques, informatique, sciences naturelles et techniques) demeurent très masculins. Sur le marché du travail, cela se traduit par des disparités en termes de rémunération et d’accès aux postes à responsabilité.

En chiffres, comment cela se traduit-il?
Les métiers de la santé, de l’enseignement et du travail social sont exercés respectivement à 86,9%, 82,3% et
80,4% par des femmes. Alors que les sciences exactes et l’ingénierie restent des bastions très masculins, puisque l’on n’y trouve que 23,5% et 9% de femmes.
En quoi est-ce grave finalement?
Ce n’est pas une question de gravité. Plusieurs recherches ont montré que les entreprises mixtes sont plus productives. Quand des secteurs entiers sont majoritairement masculins ou féminins, il y a une perte de diversité et de connaissances énorme. Deux exemples concrets: pendant des années, les tests cliniques se sont faits principalement sur les hommes, avec pour conséquence que le dosage de certains médicaments ne convient pas aux femmes. De même, dans le domaine de l’intelligence artificielle (IA), on commence à voir que l’IA a pris les biais de ses concepteurs.
Andrea Delannoy a fondé l’association Mod-Elle dans le but de lutter contre les stéréotypes de genre à l’école, qui limitent les choix de carrière chez les jeunes. Figurant sur la liste du Forum des 100 en 2022, cette économiste fait partie des personnalités les plus influentes de Suisse romande.
Chat GPT n’a jamais de réponse inclusive, il ne parle qu’au masculin! D’où l’importance pour les femmes de ne pas rater le virage numérique.
Qu’est-ce qui influence l’orientation?
La ségrégation horizontale, qui veut que filles et garçons ne fassent pas les mêmes choix professionnels, commence en fait très tôt, à l’école. Les stéréotypes de genre se cristallisent déjà à l’âge de 5 ou 6 ans. C’est là que, pour des raisons multiples, les enfants commencent à se dire: «Ce métier n’est pas pour moi.» Et c’est valable pour les deux sexes. Les garçons osent encore moins casser les codes de genre, parce qu’ils sont soumis à de fortes pressions sociales de réussite. Ils rejettent les métiers féminisés, qui sont moins bien payés, parce que ceux-ci n’incarnent pas les signes de la réussite sociale.
D’où l’idée de votre association Mod-Elle?
Oui, j’ai créé cette association pour essayer de briser ces stéréotypes. C’est pourquoi nous allons dans les classes primaires, pour présenter des femmes de tous horizons, notamment des ambulancières, des policières ou des pilotes de ligne, en uniforme. Souvent les élèves pensent qu’elles sont déguisées, que ce n’est pas leur métier. Mais à cet âge-là, les enfants n’ont pas encore trop de biais. Il est encore temps d’intervenir quand les clichés ne sont pas encore intégrés.
Pourquoi ne pas montrer des hommes dans des métiers de femme?
Mod-Elle montre des femmes de tous niveaux, en ciblant aussi les garçons. Cela permet aux filles
de s’identifier et aux garçons de prendre conscience que les femmes peuvent tout faire, tout en découvrant la myriade de métiers qui peuvent s’ouvrir à eux.
D’après vous, où sont les freins au changement?
Nous sommes encore socialisés sur la base de normes de genre, qui sont aussi vieilles que le monde. Certains de ces stéréotypes ont produit et produisent encore des préjugés, qui sont la plupart du temps inconscients. Par exemple: les filles n’aiment pas les mathématiques et les garçons sont plus doués en sciences. Ce qui a été démontré comme faux. Les freins sont donc principalement dans les têtes, d’où la difficulté de s’en débarrasser. Si l’accès aux études est aujourd’hui égalitaire, il ne présuppose pas encore l’égalité des chances. Et
1972 Naissance en Transylvanie (Roumanie). Obtient un master en économie.
2003 Arrive en Suisse, par amour.
2008-2010 obtient un master à l’Institut européen à Genève.

2010 Co-fonde l’association
Élargis tes horizons pour promouvoir les métiers MINT auprès des filles.
2012 Devient business manager à SCC Centres dans le domaine de l’orientation professionnelle pour adultes.
2018 Fonde l’association
Mod-Elle pour casser les stéréotypes de genre dans les écoles primaires.
2023 Fonde EOS Consulting, pour aider les femmes à transformer leurs aspirations professionnelles en actions concrètes.
les métiers masculins restent toujours mieux valorisés par la société.
Vous ne croyez pas à une composante génétique?
Non, pas du tout. On continue d’éduquer les petites filles à être bienveillantes et empathiques, alors qu’on encourage les garçons à jouer des coudes. J’ai grandi dans la Roumanie communiste, où les filles étaient encouragées à suivre les filières scientifiques. Et elles sont parmi les meilleures au niveau européen! Mes parents, tous deux économistes, nous ont poussées, mes sœurs et moi, à faire de hautes études. Mais, comprenez-moi bien, je ne suis pas dirigiste. Tant mieux si certaines femmes aiment rester à la maison, ce n’est pas un problème en soi. Je voudrais juste que les filles, comme les garçons, osent
À l’occasion des 25 ans de Cumulus, Migros Merge organise une fête. Rendez-vous dans la vallée, passez les 50 nouveaux niveaux et gagnez jusqu’à 10 millions de points Cumulus!



Téléchargez l’app maintenant et mettez votre adresse à l’épreuve.

transgresser les codes de genre, s’ils/elles le souhaitent.

Si tout repose sur l’éducation, est-ce aussi la faute aux jouets? Il y a plusieurs facteurs, mais les jouets renforcent souvent les rôles traditionnels. On ne trouve toujours pas de Barbie Ken infirmier par exemple… J’ai deux filles et j’ai toujours fait attention de leur donner toutes sortes de jouets, aussi bien des camions que des poupées. Elles ont aussi reçu le robot intelligent Thymio. Je n’ai pas envie que tous les garçons deviennent infirmiers ou que toutes les filles aillent à l’EPFL, mais je voudrais juste qu’ils et elles n’éliminent pas d’emblée ces métiers-là.
N’avez-vous pas l’impression que les choses sont en train de changer?
Pour chaque emballage vendu, 50 centimes sont reversés directement aux producteurs à travers des projets durables au Brésil.
30%
Tous les cafés Café Royal en grains p. ex. Espresso Impact Brasil 500 g, 7.65 au lieu de 10.95





Bien sûr, mais les mentalités évoluent lentement et nous ne pouvons pas prendre les avancées pour acquises. On constate même une régression si l’on prend les chiffres du Forum économique mondial. D’après le rapport de 2020, il fallait 100 ans à la société pour atteindre l’égalité. Cet écart est aujourd’hui estimé à 132 ans, d’après le rapport de 2022! Je pense aussi qu’il est important que les femmes arrivent au pouvoir, – seules 3% occupent des postes dans le top management de tous les secteurs en Suisse –mais qu’elles l’exercent autrement, avec cette capacité de coopération et d’empathie qu’on leur a apprise.
Qu’est-ce qui peut concrètement faire bouger les lignes? Il ne s’agit pas seulement d’ouvrir des crèches ou d’octroyer seize

semaines de congé maternité, qui ne sont pas suffisantes et qui n’impliquent pas assez le rôle du père. Seules les politiques publiques peuvent faire bouger les lignes, avec des lois qui vont dans le bon sens, comme le mariage pour tous et les quotas hommes-femmes dans les entreprises. Même s’il n’y a pas de sanctions en cas de nonapplication, ce sont des signaux importants. Les pays scandinaves, qui soutiennent vraiment la famille, sont des modèles à suivre. Ma nature optimiste me pousse à penser que l’on est sur le bon chemin. MM
Informations: conférence d’Andrea Delannoy «Les métiers ont-ils un genre», le 11 mars à l’École-club Migros à Lausanne, à 11 h, à l’occasion de la Journée de l’entrepreneuriat. Sur inscription www.ecole-club.ch
Les articles bénéficiant déjà d’une réduction sont exclus de toutes les offres. Offres valables uniquement du 7.3 au 13.3.2023, jusqu’à épuisement du stock

«D’après le rapport 2022 du Forum économique mondial, il faut 132 ans à la société pour atteindre l’égalité»
Quand les seniors partagent leur logement avec des étudiants, il y a de fortes chances pour que tout le monde en sorte gagnant. Annette Rochaix
et Nadia Russo, que soixante ans séparent, peuvent le confirmer.

Depuis le décès de son mari il y a trois ans, Annette Rochaix, 86 ans, vit seule dans la villa familiale de La Conversion (VD), entourée par les souvenirs d’une vie. Et si l’énergique Vaudoise ne s’est jamais plainte de solitude ou n’a jamais craint pour sa sécurité, ses enfants et petits-enfants se montraient parfois soucieux de la savoir isolée.
L’arrivée de Kevin Kempter dans la vie de l’octogénaire a donc été vue comme une opportunité à saisir. Le jeune homme fraîchement diplômé d’un Master of Arts en Travail social de la HES-SO aime en effet jouer les entremet-
teurs avec sa plateforme de rencontres baptisée Elderli. Il ne s’agit toutefois pas ici de trouver l’amour, mais un colocataire. «Une amie m’a parlé de celui que j’appelle maintenant Monsieur Elderli en rigolant. Même si ce n’est pas anodin d’accueillir quelqu’un chez soi, j’ai décidé de l’appeler, et nous nous sommes rencontrés une première fois l’automne dernier.»
Durant cette phase initiale, le responsable d’Elderli cherche à connaître les motifs et – surtout – les exigences des seniors en termes de vie commune. Sont-ils par exemple prêts à partager la
Kevin Kempter, responsable de la plateforme Elderlisalle de bain, accepteraient-ils que le colocataire organise des fêtes, y a-t-il des tâches ménagères que l’étudiant devrait effectuer? Cette étape est décisive, car par la suite Kevin Kempter doit partir à la recherche de la perle rare afin de créer un binôme.
Une vie sociale
Lors de ses démarches, notre homme se concentre sur les étudiants afin de donner une dimension intergénérationnelle à son projet et, partant, de donner du sens à son travail. «Partager un appartement ou une maison
Texte: Pierre Wuthrich Photo: Nicolas Righetti / Lundi13«Pour la famille, c’est rassurant de savoir qu’une jeune personne habite avec le senior»
permet à la personne âgée de voir son revenu augmenter tout en lui apportant un peu plus de vie sociale et, peut-être, la possibilité de rester chez elle plus longtemps. Pour les proches aidants ou la famille, c’est aussi rassurant de savoir qu’une jeune personne habite avec le senior. Cela permet d’apaiser certaines craintes. Enfin, pour les étudiants, Elderli offre de nouvelles possibilités d’hébergement dans un marché immobilier saturé», résume Kevin Kempter. Étudiante en droit à l’Université de Lausanne, Nadia Russo, 26 ans, a emménagé chez Annette
une seconde petite cuisine a été aménagée pour Nadia Russo dans l’ancien studio de photo du mari d’Annette Rochaix. «Nous buvons chaque matin le café et papotons un peu. Parfois, on regarde la télé ensemble. Dès le printemps, nous partagerons aussi le jardin et la piscine», se réjouit l’octogénaire.
Une structure professionnelle Nous avons affaire ici à une version plutôt confort de la colocation, «mais il existe aussi des binômes qui vivent dans un 3,5 pièces», précise Kevin Kempter qui a déjà fait se rencontrer cinq paires depuis le lancement d’Elderli en 2022 et qui vise d’ici un an la cinquantaine de duos.
Le Fonds national suisse et Innosuisse soutiennent le travailleur social dans le cadre du programme Bridge: Proof of Concept. Pour ces institutions, le projet est innovant et présente un potentiel de développement intéressant grâce à sa structure professionnelle qui encadre les participants à Elderli. En effet, afin que les colocations se déroulent sans anicroches, Kevin Kempter et son équipe assurent un suivi avec des rencontres mensuelles. «S’il y a des problèmes, ils sont alors mis sur la table, et il est souvent possible de les régler facilement.»
Rochaix en fin d’année dernière et ne regrette pas son choix. «Je vivais avant avec d’autres étudiants mais c’était bruyant. Ici, c’est très calme et je peux me concentrer. Par ailleurs, je peux m’intégrer plus facilement ici. En étant sur le campus, on reste avec d’autres étudiants et on est un peu déconnecté de la vie. Mais pas ici. Avec Annette en décembre, nous avons participé par exemple à une fête de quartier et j’ai pu faire connaissance de tous nos voisins.»
Concrètement, les deux femmes ont chacune leur espace. Les salles d’eau sont séparées, et
De plus, Elderli se charge des démarches administratives – pour établir le contrat de colocation ou annoncer l’arrivée de l’étudiant dans une commune par exemple –et offre une assistance 7/7. «J’ai de plus constitué un stock de chambres de réserve si je devais reloger une personne en urgence, par exemple suite au décès d’un senior ou à une mésentente marquée.» Pour les colocataires, cela a un coût: 90 francs par mois. Mais ni Annette Rochaix ni Nadia Russo n’y trouvent quelque chose à redire. Au point que les deux femmes font désormais chacune de leur côté de la publicité pour Elderli dans leur cercle d’amis et de connaissances. MM En savoir plus: elderli.ch
 Nadia Russo et Annette Rochaix ont chacune leur espace dans la villa familiale de l’octogénaire.
Nadia Russo et Annette Rochaix ont chacune leur espace dans la villa familiale de l’octogénaire.
«En étant sur le campus, on est un peu déconnecté de la vie. Mais pas ici»
Nadia Russo, étudiante en droit


























Visite notre Site web


En vente dans les plus grands magasins Migros. Les articles bénéficiant déjà d’une réduction sont exclus de toutes les offres. Offres valables uniquement du 7.3 au 20.3.2023, jusqu’à épuisement du stock



Nouveau
Ardell Nail Addict LED-Gel-Lampe Lampe à gel LED légère et compacte avec port USB, par pièce 19.90











Nouveau

Ardell Clear Nail Gel Gel scellant professionnel avec pinceau d’application inclus, par pièce 17.90











Texte: Jeannette Schaller
Vous payez des intérêts sur le crédit de votre appartement ou de votre maison. Vous pouvez les déduire de votre revenu imposable. Par exemple, si vous payez 2000 francs d’intérêts la première année, vous pouvez économiser 400 francs (dans l’hypothèse d’un taux d’imposition marginal de 20%). Les intérêts supérieurs à 50 000 francs ne sont pas déductibles, mais les particuliers atteignent rarement de tels montants.
Procédure Dans le formulaire «État des dettes» de la déclaration d’impôts figure une rubrique «Dettes privées». Inscrivez-y les données relatives aux intérêts déductibles et au solde restant dû. S’il y a plusieurs crédits, vous les mentionnez tous séparément.
Exception Les intérêts sur les crédits de construction et les droits de superficie ne sont pas déductibles auprès de la Confédération et de la plupart des cantons.
Conseil D’un point de vue fiscal, il peut ne pas être intéressant d’amortir l’hypothèque. En déduisant les intérêts, vous pouvez réduire l’imposition de la valeur locative.
Si vous habitez un logement en propriété, vous devez payer des impôts. Il s’agit d’un revenu fictif, appelé «valeur locative». Il correspond aux revenus locatifs que vous pourriez obtenir pour votre appartement ou votre maison. Selon le canton, la valeur locative est inférieure d’environ 20 à 40% au loyer d’un bien comparable. Dans la déclaration d’impôts, la valeur locative est ajoutée au revenu imposable, ce qui signifie que plus la valeur locative est élevée, plus la charge fiscale est importante.

Procédure Faites vérifier la valeur locative officiellement fixée par un(e) spécialiste de la fiscalité. En effet, dans certains cas, cette valeur peut être surévaluée. Vérifiez aussi si votre canton de résidence prévoit une réglementation des cas de rigueur: dans le canton de Zurich, par exemple, la valeur locative ne doit pas représenter plus d’un tiers des revenus dont un ménage a besoin pour vivre (avec un plafond de fortune défini).
Après le départ des enfants, le décès du partenaire ou après un divorce, des pièces restent souvent subitement inutilisées. Auprès de la Confédération et dans douze cantons, vous avez ainsi droit à une valeur locative plus basse (après une déduction pour sous-utilisation): BL, FR, GL, GR, NW, OW, SG, SH, SZ, UR, ZG et ZH Toutefois, des conditions strictes sont souvent appliquées. Ainsi, la pièce qui n’est plus utilisée doit être entièrement vide ou non meublée. Vous ne pouvez pas faire valoir la déduction pour un débarras.
Procédure Déposez une demande en annexe à la déclaration d’impôt pour obtenir une déduction pour sous-utilisation. Motivez votre demande et indiquez une valeur locative correspondante inférieure. La déduction pour sous-utilisation ne s’applique que pour la période fiscale en cours. À chaque déclaration d’impôt, vous devez déposer une nouvelle demande.
Exception Pour les résidences secondaires, une telle déduction n’est pas possible.
La même règle s’applique à la résidence secondaire qu’au logement en propriété: vous devez déclarer la valeur locative comme revenu. Parallèlement, vous pouvez déduire de votre revenu les frais d’entretien qui y sont engagés. Sont également déductibles, comme pour la propriété par étage au domicile, les frais de gestion par un tiers et les versements au fonds d’entretien pour la propriété par étage. En cas de location, vous devez payer des impôts sur le revenu locatif. La valeur locative s’en trouve réduite.
Vous avez remplacé votre chauffage ou rénové votre douche? Vous pouvez alors déduire ces frais d’entretien de votre revenu imposable. Sont considérés comme frais d’entretien les travaux de peinture, de réparation et de plomberie ainsi que les mesures de protection de l’environnement et d’économie d’énergie. Vous pouvez également déduire un montant forfaitaire.
Procédure Les déductions forfaitaires sont généralement comprises entre 10 et 20% de la valeur locative ou des revenus locatifs (si vous louez un logement). Cependant, dans de nombreux cas, les frais d’entretien sont nettement plus élevés, surtout pour les immeubles plus anciens et les rénovations à effectuer. Il est alors conseillé de déclarer les coûts réels.
Exception Si vous transformez par exemple les combles en appartement, il s’agit d’un investissement «à valeur ajoutée». Vous ne pouvez donc pas les déduire de votre revenu imposable, contrairement à un investissement purement «de maintien de la valeur». Les dépenses relatives à l’économie d’énergie pour une pompe à chaleur ou des panneaux solaires sont toutefois déductibles.
Conseil Échelonnez les travaux de rénovation sur plusieurs années. Il peut être intéressant, en particulier pour les projets de grande envergure, d’étaler les rénovations sur deux ou plusieurs années civiles.
En tant que bailleur, vous pouvez également déduire de votre revenu imposable les intérêts et les frais d’entretien de l’immeuble loué. La différence entre les revenus locatifs d’une part et les intérêts et les frais d’entretien d’autre part est imposée comme un revenu. En revanche, aucune valeur locative n’est due, car vous n’habitez pas votre logement.
Exception Si vous laissez votre maison ou votre appartement en location à un enfant à un taux préférentiel, il se peut que vous deviez quand même payer des impôts sur la différence entre le loyer et la valeur locative. Dans certains cantons, vous devez de toute façon vous acquitter des impôts sur la valeur locative.

Il existe également un potentiel d’économie lors du remboursement de votre hypothèque dans le cadre de la possession d’un logement habité par son propriétaire. Important: ne remboursez pas l’hypothèque par tranches ou directement, mais amortissez-la autant que possible indirectement, en la compensant à la fin de la durée avec le capital 3a que vous avez versé. Vous bénéficiez ainsi de deux avantages fiscaux: premièrement, le versement dans le pilier 3a réduit votre revenu imposable. Deuxièmement, vous pouvez déduire l’intégralité des intérêts sur toute la période. Un remboursement de l’hypothèque à partir des fonds du pilier 3a est autorisé tous les cinq ans. MM
Ces conseils ne sont pas exhaustifs. Pour une planification et des conseils rigoureux, veuillez vous adresser à un(e) expert(e) en fiscalité ou à votre banque habituelle.
Jeannette Schaller, responsable de la planification financière à la Banque Migros.

L’emballage des fameux lapins de Pâques colorés de Frey est désormais fabriqué à partir de pommes de terre. Une enveloppe plus durable, dont la conception a pris deux ans. Texte: Edita Dizdar.
Pourquoi les lapins de Pâques Frey ont-ils un nouvel emballage?


«Nous voulions trouver une alternative 100% recyclable à la coque en PET métallisé, qui ne pouvait être jetée qu’avec les ordures ménagères», explique Roger Zollinger, spécialiste des emballages chez Delica AG. Le nouvel emballage en fibre moulée, quant à lui, peut être éliminé dans la collecte sélective des cartons. Le lapin au chocolat est le premier produit Migros à être présenté dans un emballage de ce type.
De quoi est faite cette nouvelle enveloppe?


Elle se compose en grande partie d’amidon de pomme de terre. Celui-ci est obtenu à partir des déchets de la production de frites. Le reste provient des pommes de terre industrielles. On y ajoute des fibres de papier et de l’eau.
Quelles sont les propriétés des pommes de terre industrielles?
Contrairement aux pommes de terre alimentaires, les pommes de terre industrielles ont une teneur en amidon beaucoup plus élevée. Elles ne sont pas adaptées à la consommation directe et sont plutôt utilisées comme moyens auxiliaires, par exemple dans la fabrication de papier, de carton ou de colle. Et comme on peut le voir, maintenant aussi pour les emballages.
La production des pommes de terre industrielles est-elle vraiment durable?
Chaque matière première a un certain bagage en termes d’impact environnemental.
«Je vois les choses ainsi: nous avons fait un pas très important dans la bonne direction en transformant un emballage non recyclable en emballage recyclable», explique Roger Zollinger.
www.stannah.ch


sales@stannah.ch
Monte-escaliers Stannah, vivre de façon indépendante à la maison
L’installation d’un monte-escalier est une décision familière. Nous sommes fiers de fournir aux habitations suisses les monte-escaliers les plus sûrs et durables du marché.



Merci de m’envoyer vos informations gratuites !
Nom: Prénom:
Produits de qualité excellente

Service Clients 24h/7

Fabricant depuis 156 ans

Quelle quantité de plastique Migros économise-t-elle avec ce nouvel emballage?
Sur l’ensemble des trois formats de lapins de Pâques, Migros économise 6000 kg de plastique.
N’aurait-on pas pu simplement vendre les lapins dans des sacs transparents?
Oui, naturellement. «Toutefois, les clientes et clients de Migros n’auraient plus trouvé ce produit très apprécié dans les rayons. Les caractéristiques du lapin auraient complètement disparu. Nous voulions éviter ce désagrément», explique Roger Zollinger.


Comment l’emballage en fibre moulée est-il évalué dans le M-Check?




Selon le format, les trois lapins de Pâques ont entre trois et quatre étoiles. L’emballage est recyclable et a une faible empreinte environnementale, mais il est plutôt lourd par rapport au poids du chocolat. C’est pourquoi on ne leur a pas attribué cinq étoiles. «Nous travaillons cependant à alléger l’enveloppe», ajoute Roger Zollinger.


Combien de temps a duré la conception du nouvel emballage?
Environ deux ans de manière intensive. Une équipe créative s’est mise au travail au début de l’année 2020 Après une longue recherche de fournisseurs, la production a démarré à la fin de l’année 2022
Quels ont été les obstacles les plus importants?
«L’emballage, en contact direct avec le lapin, devait être sans danger, ce qui n’était pas si simple. De même, la recherche d’un fournisseur capable de fabriquer la forme souhaitée s’est avérée laborieuse. Enfin, la fermeture a également constitué un défi, car les deux moitiés de la coque doivent s’emboîter et tenir ensemble», conclut Roger Zollinger. MM
Au Moyen Age déjà, les gens accomplissaient le pèlerinage de Saint-Jacques de Compostelle jusqu’au tombeau de l’apôtre Jacques, découvert au 9e siècle. On érigea alors une église près de la sépulture, autour de laquelle fut fondée la ville de SaintJacques de Compostelle. Le chemin jusqu’à l’extrémité occidentale de l’Espagne était pénible et le parcourir pouvait prendre des mois. Une fois arrivés, les pèlerins allaient poser le front sur la colonne de Saint-Jacques – une tradition qui se perpétue encore! Ce beau voyage combine quelques randonnées faciles sur les chemins de Saint-Jacques avec les grands sites du nord de l’Espagne.
Votre programme de voyage
1er jour, mardi 16 mai 2023 – Vol pour Bilbao Vol Genève-Bilbao via Munich, puis transfert en car à notre hôtel de Pampelune
2e jour, mercredi 17 mai 2023 – Pampelune
– Burgos
La journée débute par un tour de ville. On suppose que la ville chargée d’histoire de Pampelune a été fondée en 75 avant J.-C. par le général romain Magnus, mais c’est aux pèlerins de Saint-Jacques qu’elle doit son développement.
Nous verrons bien sûr l’imposante cathédrale construite au 15e siècle. Repas de midi avant de débuter notre première petite randonnée jusqu’à Puente la Reina (env. 4 km), où les deux principaux chemins de Compostelle se rejoignent. En car, nous continuons ensuite vers Santo Domingo de la Calzada, site du miracle du Pendu dépendu. Arrivée à Burgos, notre étape du jour.
3e jour, jeudi 18 mai 2023 – Burgos – León Visite de la célèbre cathédrale de Burgos avant de repartir dans le courant de la matinée. Entre Rabe de las Calzadas et Hornillos, nous faisons une seconde randonnée (env. 8 km), puis reprenons la direction de Fromista et sa remarquable église romane San Martin. Nuit à Léon.
4e jour, vendredi 19 mai 2023 – León –Ponferrada
A León, nous visitons la basilique Saint-Isidore et son Panthéon royal, la cathédrale (entrée incluse) et l’Hospice San Marco (visite extérieure). En car, nous rejoignons ensuite l’ancien chemin pèlerin de Foncebadón, où nous marchons d’abord de Foncebadón à Cruz de Hierro (env. 4 km en légère montée). En car, nous continuons jusqu’à El Acebo, puis reprenons notre marche à travers les beaux paysages menant à Molinaseca (8 km, dénivelé de 570 m en descente). Le car nous y attend pour nous conduire à Ponferrada, notre étape pour la nuit.
5e jour, samedi 20 mai 2023 – Ponferrada –Saint-Jacques de Compostelle

Deux églises majeures figurent au programme de la matinée: nous débutons par la visite de l’église Santiago de Villafranca del Bierzo, suivie de celle de Santa Maria à Melide. La dernière randonnée du voyage (env. 5 km) nous conduit à Boente, à travers champs et forêts. Depuis le Mont de la Joie, un peu avant Saint-Jacques, nous pouvons déjà apercevoir les tours de la cathédrale mondialement renommée. A SaintJacques, une balade guidée (cathédrale incluse) à travers la vieille ville nous mène jusqu’à la tombe de l’apôtre Jacques. Nuit à Saint-Jacques de Compostelle.


6e jour, dimanche 21 mai 2023 – SaintJacques de Compostelle – Oviedo En route pour Oviedo, nous suivons aujourd’hui les paysages pittoresques de la Costa Verde. C’est à Oviedo, dans la «Cámara Santa» de la cathédrale, qu’est conservé un coffre sacré contenant de précieuses reliques. Un passionnant tour guidé nous attend à Oviedo. Nuit à Candas.
7e jour, lundi 22 mai 2023 – Candas – Bilbao
Trajet jusqu’à Bilbao, où 700 ans d’histoire contrastent avec d’emblématiques édifices d’architecture moderne. Point culminant de cette fin de voyage, la visite du musée Guggenheim.
Conçu par Frank O. Gehry, ce bâtiment de rayonnement international fait d’acier, de verre, de calcaire et de titane est tout simplement fascinant. Temps libre en fin de visite. Nuit à Bilbao.
8e jour, mardi 23 mai 2023 – Vol retour
Il est temps aujourd’hui de prendre congé de l’Espagne. Transfert à l’aéroport et vol pour rentrer à Genève, via Munich.
Toutes les randonnées sont accompagnées par un guide local expérimenté. Des facteurs extérieurs, des conditions météo défavorables ou l’effectif des groupes peuvent rendre nécessaire l’ajustement de certaines randonnées.
8 jours, demi-pension incluse, dès
✓ Vol Lufthansa de Genève à Bilbao via Munich et retour, en classe Economy
✓ Toutes les taxes, frais et supplément carburant inclus (Euro 41.-, état 3/2023)
✓ Circuit en car spécial tout confort
✓ 7 nuits en hôtels de classe moyenne supérieure
✓ 7 x petit déjeuner à l’hôtel
✓ 7 x repas du soir à l’hôtel
✓ Guide chevronné pour les randonnées/ accompagnant pour tout le voyage
✓ Visite guidée de Pampelune
✓ Visite guidée de la cathédrale de Burgos, entrée incluse

✓ Visite guidée de León, entrée à la cathédrale incluse
✓ Visite guidée de Saint-Jacques de Compostelle

✓ Visite guidée d’Oviedo

✓ Entrée à la cathédrale de Saint-Jacques de Compostelle, avec audio-guide
✓ Entrée au musée Guggenheim, avec audio-guide
✓ Assistance de notre propre guide suisse pendant tout le voyage
Notre prix spécial pour vous
Prix par personne en chambre double en hôtels de classe moyenne supérieure
Fr. 1999.-
Non inclus/en option:
Supplément chambre individuelle: Fr. 399.Frais de réservation: Fr. 24.- par personne (supprimés pour les réservations en ligne)
Vols: Genève-Bilbao et retour, via Munich (à l’aller comme au retour)
Economisez encore plusChèques REKA acceptés à 100%!
Bilbao Puente la Reina Santo Domingo de la Calzada Hornillos Fromista Foncebadón El Acebo Villafranca del Bierzo Melide Candas Pamplona Burgos León Ponferrada Santiago de Compostela Oviedo Mar C antabric o Visite guidée de Pampelune Molinaseca Saint-Jacques de CompostelleUn fantastique circuit de randonnées dans le nord de l’Espagne
Pour faire briller la maison, les nouveaux produits concentrés «Add Water» de Migros Plus se mélangent avec de l’eau du robinet pour déployer toute la puissance de leur agent détergent et s’utilisent comme d’habitude. Les concentrés sont disponibles sous forme de liquide vaisselle et de détergent pour la salle de bains et pour les vitres. Lorsque la bouteille est vide, il suffit de la remplir avec le sachet de recharge concentré et d’y ajouter à nouveau de l’eau du robinet. Ainsi, la consommation de plastique est réduite de 90%. En outre, les produits sont plus légers à transporter, ce qui libère moins d’émissions de CO2

Liquide vaisselle Migros Plus*, concentré, 500 ml Fr. 4.10
Spray détergent pour salle de bains Migros Plus*, concentré, 500 ml Fr. 4.10
Spray détergent pour vitres Migros Plus*, concentré, 500 ml Fr. 4.10
Tous les sachets de recharge Migros Plus*, concentré, 300 ml chacun Fr. 4.90
* En vente dans certains magasins Migros.
* Points Cumulus multipliés par 20 sur tous les produits «Add Water» de Migros Plus jusqu’au 13 mars. 20 × Cumulus *POINTS FORTS
• Le viaduc de Millau, un ouvrage d’exception
• Les couteaux de Laguiole, un sublime savoir-faire
• Dégustation d’aligot au buron de Camejane
Du 22 au 27 mai, du 17 au 22 juillet*, du 4 au 9 septembre ou du 9 au 14 octobre 2023
Les plus beaux villages de France

Ici, pas d’ennui ! Avec de magnifiques plateaux en vallées, vous serez totalement dépaysé en Aveyron. Vous pourrez, sur les pas des pèlerins de Saint-Jacques-de-Compostelle, découvrir une nature authentique. Hôtel 3*, pension complète
DÈS
1’850.PAR PERSONNE EN CHAMBRE DOUBLE 9 JOURS
Du 18 au 24 juin 2023
Tout un monde dans un petit pays
Andorre, c’est avant tout l’ivresse des hauts sommets, des paysages superbes, des chemins de randonnée toute catégorie dans des zones protégées de nature sauvage et des lacs. Hôtels 3* et 4*, pension complète (sauf jour 6)

POINTS FORTS
• Balade au lac d’Engolasters, presque comme au Canada
• Andorre-la-Vieille, plus haute capitale d’Europe
• Dîner typique dans une authentique auberge de montagne
ESPAGNE
Du 22 au 30 juin ou du 22 au 30 septembre 2023
Une rencontre unique avec la côte nord de l’Espagne
La Cantabrie est une communauté autonome du nord de l’Espagne. Un voyage VIP inédit dans l’Espagne Verte, entre visites de villes, musées, découvertes de parcs naturels et de plaisirs de la table. Hôtels 3* et 4*, 2 dîners et 6 soupers
POINTS FORTS
• L’une des plus belles baies au monde à Santander

• Le célèbre parc naturel des Pics d’Europe
• Le pont suspendu de Getxo
Lieux de départ au plus près de chez vous, depuis les cantons de GE, FR, NE, VD et VS
Le coup de fendant du patron Voyage en car 4* tout confort
Accompagnatrice Buchard Boissons gratuites à bord du car

Ingrédients pour 4 personnes
50 g d’ail des ours
100 g d’épinards à salade
3 cs d’huile d’olive Sel, poivre
9 dl de lait coupé d’eau (moitié lait, moitié eau), p. ex. avec lait d’avoine
150 g de semoule de maïs fine 80 g de parmesan râpé
1. Rincer l’ail des ours et les épinards. Chauffer un peu d’huile dans une casserole et y ajouter les feuilles encore mouillées. Couvrir et faire étuver jusqu’à ce qu’elles tombent. Ajouter le reste de l’huile et réduire le tout en fine purée à l’aide d’un mixeur plongeur. Relever de sel.
2. Amener le lait coupé à ébullition et saler légèrement. Y verser la semoule de maïs en une seule fois, remuer vigoureusement avec un fouet puis faire mijoter env. 2 min en remuant. Retirer la casserole du feu, saler et poivrer. Incorporer le parmesan et servir la polenta avec la purée d’épinards à l’ail des ours. Temps: env. 20 minutes.
Cette plante parfumée pousse dans les sous-bois dès la fin de l’hiver. Il faut alors se dépêcher de la cueillir, car sa saison est courte. Son goût intense relève à merveille de nombreux plats.
Feta croustillante à l’ail des ours sur salade


Ingrédients pour 4 personnes
400 g de feta
20 g d’ail des ours
200 g de panko (chapelure japonaise)
4 cs de farine
2 œufs
4 cs de beurre à rôtir
Salade
4 cs d’huile de tournesol
3 cs de vinaigre aux herbes
1 cs de moutarde à gros grains
1 cc de miel liquide
Sel, poivre
400 g de laitue à tondre mélangée
1. Couper la feta en bâtonnets d’env. 1,5 cm d’épaisseur. Rincer l’ail des ours, bien l’éponger puis le hacher fin et le mélanger avec le panko dans une assiette creuse. Verser la farine et battre les œufs dans deux autres assiettes creuses. Tourner les bâtonnets dans la farine puis les passer dans l’œuf et finalement les presser dans le panko. Chauffer le beurre dans une poêle. Faire croustiller les bâtonnets de feta par portions durant env. 2 min.
2. Dans une jatte, mélanger l’huile, le vinaigre, la moutarde et le miel. Relever de sel et de poivre. Ajouter la salade et mélanger. Dresser la salade et les bâtonnets de feta sur des assiettes.
Temps: 34 minutes.
Cette spécialité des Grisons connue sous le nom de capuns est ici enveloppée d’une feuille d’ail des ours pour encore plus de saveurs et de caractère.
CONSEIL
Normalement l’ail des ours est récolté avant la floraison. Cependant, les petits bourgeons encore fermés peuvent aussi être utilisés.
CONSEIL
Ingrédients pour 4 personnes
2 bottes de carottes
1 cs de beurre
1 cs d’huile
0,75 dl d’eau

2 cs de miel de nectar liquide
1 cs de vinaigre, p. ex. condimento bianco
10 g de petites feuilles et de bourgeons d’ail des ours
1. Raccourcir les fanes des carottes à env. 5 cm. Si utilisées non épluchées, bien rincer les carottes et les brosser. Selon leur taille, les laisser entières ou les couper en deux dans la longueur. Chauffer le beurre et l’huile. Y faire revenir les carottes env. 5 min puis saler généreusement. Ajouter l’eau et faire mijoter jusqu’à évaporation presque totale du liquide et en gardant les carottes à peine croquantes. Verser le miel et le vinaigre, bien mélanger, puis ajouter l’ail des ours, remuer et servir aussitôt. Temps: env. 20 minutes.

CONSEIL
Dans cette version très aromatique du fameux dip à base d’avocat, la coriandre est remplacée par de l’ail des ours. Un résultat qui affole les papilles.
Lors de la cueillette sauvage, attention à ne pas confondre les feuilles de l’ail des ours, molles et brillantes dessus, avec celles toxiques du muguet et du colchique d’automne, nettement plus rigides.
Le guacamole à l’ail des ours est un dip savoureux qui se glisse aussi volontiers dans un wrap ou un burger.Toutes les recettes se trouvent sur migusto.ch


















Pourquoi l’ail des ours donne-t-il mauvaise haleine?
Comme avec l’ail, lorsque l’on broie l’ail des ours, il se forme un composé sulfuré appelé allicine qui répand une odeur qui en rebute plus d’un. Ce violent dégoût pour les odeurs de soufre remonte probablement aux temps anciens: autrefois, elles pouvaient indiquer un danger, par exemple un élément en putréfaction ou des gaz toxiques émis par un volcan.
Pourquoi ne sent-on pas sa propre haleine?
Difficile à comprendre, car après tout, quand on mange de l’ail des ours, on est soi-même la source de cette odeur. Cependant, le nez ne peut percevoir les odeurs dans toute leur intensité que pendant un court instant avant d’être en quelque sorte saturé par les stimuli. On ne sent donc plus rien et on ne comprend pas pourquoi les autres nous tournent le dos avec horreur.
Est-ce
se brosser les dents et de faire un bain de bouche?
Non, car le corps n’absorbe l’allicine et ses sous-produits que par l’estomac et l’intestin avant de passer dans le sang. Ensuite, l’odeur de soufre se diffuse par les poumons et les émanations de la peau. Cette puanteur ne vient donc pas seulement de la gorge: tout le corps se transforme pour ainsi dire en soufrière.
L’odeur de l’ail des ours peut être aussi nauséabonde que celle tant redoutée de l’ail. Il existe pourtant des remèdes maison pour éviter ce désagrément.
Texte: Michael West
Manger une pomme fraîche est particulièrement efficace: ses enzymes brisent le composé de soufre et combattent le mal à la racine. On peut aussi sucer une rondelle de citron ou mâcher de la menthe fraîche. Les huiles essentielles contenues dans le citron et les herbes retiennent l’odeur, du moins temporairement. De nombreuses personnes ne jurent en outre que par les pilules à la chlorophylle, que l’on trouve sans ordonnance en pharmacie. Non seulement elles masquent la mauvaise odeur, mais elles agissent de l’intérieur grâce à la chlorophylline de cuivre sodique.
Comment ne pas faire fuir son ou sa partenaire?
faire contre l’odeur de l’ail des ours sur les doigts?
Lorsque l’on cuisine un plat avec de l’ail des ours, l’odeur de soufre reste ensuite sur les mains. On peut les frotter par exemple avec un peu de sel et de jus de citron, laisser agir le mélange quelques instants et les laver ensuite à l’eau tiède, ou encore avec du bicarbonate de soude avant de les rincer.
Si vous voulez déguster des spaghettis avec un pesto à l’ail des ours ou encore un risotto ou des spätzlis à l’ail des ours, par exemple, faites à tout prix en sorte de manger en même temps que votre partenaire: ainsi, la mauvaise haleine ne créera pas de distance entre vous deux! MM

20x
Nouveau
4.95





Offres valable du 7.3 au 20.3.2023, jusqu’à épuisement du stock. Les articles bénéficiant déjà d’une réduction sont exclus de toutes les offres.












Le Petit Marseillais Savon certifié bio Rose sauvage, pH neutre, 290ml








Au cœur d’un centre commercial situé à proximité de l’autoroute et de nouvelles zones résidentielles, le supermarché Migros du Quartz à Martigny est très apprécié de ses voisins, des pendulaires et des touristes.
Texte: Fabien Lafarge Photos: Raphaël Fiorina
CARTE D’IDENTITÉ: Migros Quartz
Ouverture: 2012
Gérant: Julien Müller
Collaborateur: 45 (supermarché, SportXX et melectronics)

Particularités: proximité de l’autoroute, grand parking, centre commercial avec de nombreuses enseignes
Julien Müller, vous êtes gérant depuis le 1er avril 2019. Présentez-nous votre environnement de travail.
Migros a ouvert ce supermarché au Quartz en 2012, avec un melectronics, un SportXX et deux autres enseignes Migros qui, depuis, ont fermé. Je suis donc à la tête d’une belle équipe, qui réunit quarante-cinq personnes, dont six apprentis, entre le supermarché et les marchés spécialisés.

Le Centre Quartz est installé en périphérie de Martigny, en quoi est-ce un avantage?
Nous attirons une clientèle très large, grâce à une situation idéale
juste à côté de la sortie d’autoroute et un très grand parking. Nous accueillons donc des habitants des quartiers environnants en plein développement, mais également des pendulaires et des touristes. C’est très facile de s’arrêter chez nous pour des courses à la sortie du travail ou lorsque l’on se rend en station pour le week-end ou les vacances, car nous sommes sur la route de toutes ces personnes.
Le tout dans un centre commercial qui offre un large choix d’articles...
De nombreuses enseignes sont présentes depuis des années,
par exemple pour la téléphonie, le prêt-à-porter ou encore pour la restauration. Dernièrement, un parc de loisirs pour les enfants a même ouvert ses portes, ce qui attire une clientèle variée et familiale. On peut ajouter également que les propriétaires du centre sont très dynamiques: ils mettent sur pied des décorations et des animations pour chaque fête qui rythme l’année. Sans
mauvais jeu de mots, ce quartz est un vrai bijou!
Et comment est l’ambiance de travail au Quartz? Nous avons la chance d’avoir un noyau de personnes présentes depuis le début et qui connaissent très bien le fonctionnement de Migros. L’ambiance est très bonne et cela se ressent sur la clientèle qui apprécie toujours ses visites chez nous. MM
AVANTAGES mardi 7|3

31%
Les articles M-Budget ou bénéficiant déjà d’une réduction sont exclus de toutes les offres. Offres valables du 7.3 au 13.3.2023, jusqu’à épuisement du stock.


dans
nos magasins
Société coopérative Migros Valais



 3.40 au lieu de 4.95
Fraises, Bio Italie/Espagne barquette 400 g
tous
3.50 Citrons, Bio Italie, le kg
3.40 au lieu de 4.95
Fraises, Bio Italie/Espagne barquette 400 g
tous
3.50 Citrons, Bio Italie, le kg
Le CERM à Martigny se prépare à accueillir début mars le Salon des Métiers et de la Formation «Your Challenge». Des jeunes et moins jeunes de tout le canton pourront y découvrir de nombreuses professions. Migros Valais y sera.
 Fabien Lafarge
Fabien Lafarge
Du 8 au 13 mars, écoliers, étudiants ou adultes soucieux de leur avenir professionnel pourront se rendre au CERM à Martigny afin de découvrir plus de 75 exposants et 400 professions, dans le cadre du Salon des Métiers et de la Formation.
Commencer sa carrière à Migros Valais
Faire son apprentissage à Migros Valais, c’est bénéficier des atouts d’une grande entreprise qui accorde beaucoup d’importance à la qualité ainsi qu’au suivi de la formation. L’entreprise possède en effet une équipe dédiée au bien-être et à la réussite des jeunes apprenants. Celle-ci sera présente à Martigny pour présenter son travail d’appui et d’accompagnement ainsi que les différentes formations proposées par la coopérative. Pour s’informer, il sera aussi possible de s’entretenir chaque jour avec quatre apprenties et apprentis de métiers différents. Ils répondront à toutes les

questions sur le contenu de la formation, sa durée, sur le lieu des cours et l’organisation de l’apprentissage en entreprise. Ce n’est pas tout, le stand Migros Valais proposera de nombreuses animations, à savoir un jeu de
réflexe, un concours avec trois bons de Fr. 100.– à gagner et un quiz sur écran tactile. MM
Rendez-vous donc au CERM à Martigny les mercredi 8, jeudi 9, vendredi 10 et lundi 13 de 8 h à 17 h ainsi que samedi 11 et dimanche 12 de 10 h à 17 h.
Tous les deux ans, pendant six jours, l’essentiel des métiers et des filières de formation existantes en Valais et en Suisse romande se retrouve au CERM de Martigny.
Le FVS groupe est l’organisateur du salon, en collaboration avec l’État du Valais et l’Union valaisanne des arts et métiers (UVAM).
Bilingue et intégré au programme valaisan de formation professionnelle, «Your Challenge» met tout en œuvre pour proposer un salon dynamique et attrayant qui soit le plus complet possible.
Toutes les informations se trouvent sur le site www.yourchallenge.ch Pour découvrir toutes nos offres de places d’apprentissage encore disponibles, scannez le code QR ci-dessous ou rendez-vous sur www. groupe-migros.jobs






20%




Les articles M-Budget ou bénéficiant déjà d’une réduction sont exclus de toutes les offres. Offres valables du 7.3 au 13.3.2023, jusqu’à épuisement du stock.













 Société coopérative Migros Valais
4.95 Lapin géant au lait 440 g
14.50 La Colomba di Verona 1 kg
4.40 Biscuits Lapins de Pâques 400 g
5.75 au lieu de 7.20
Gâteau de Pâques 475 g
8.10 La Colomba Classica 500 g
18.60 La Colomba artigianale 500 g
12.80 La Colomba Cioccolata ou Tiramisu 750 g
Société coopérative Migros Valais
4.95 Lapin géant au lait 440 g
14.50 La Colomba di Verona 1 kg
4.40 Biscuits Lapins de Pâques 400 g
5.75 au lieu de 7.20
Gâteau de Pâques 475 g
8.10 La Colomba Classica 500 g
18.60 La Colomba artigianale 500 g
12.80 La Colomba Cioccolata ou Tiramisu 750 g















Offres valables uniquement dans les plus grands magasins. Offres valables du 7.3 au 13.3.2023, jusqu’à épuisement du



• Comble immédiatement les rides






• Une utilisation régulière permet d’atténuer les rides profondes
















• Avec Q10 pur & peptides Bioxifill®











Vous voulez participer à une course populaire cette année, mais c’est la première fois? Voici quelques conseils d’expert pour une première expérience inoubliable.
Texte: Susanne Schmid Lopardo
Si vous participez pour la première fois à une course populaire, ne vous fixez pas de limite de temps. Prenez la résolution de participer et de terminer la course. Arriver est votre objectif! Et participez à une course populaire qui n’a pas lieu demain!
tout de suite
Intégrez dès maintenant beaucoup d’activité physique dans votre quotidien. Allez au travail à pied ou à vélo et prenez les escaliers plutôt que l’ascenseur. De plus, planifiez des entraînements de course ciblés au moins deux ou trois fois par semaine.
Ne pas trop forcer au début Commencez par des séances de vingt minutes, durant lesquelles vous alternez une minute de jogging et une minute de marche. Ensuite, vous pourrez augmenter progressivement la durée du jogging et réduire celle de la marche. Dès que vous parvenez à courir vingt minutes d’affilée, vous pouvez augmenter la durée de votre entraînement. «Le corps a besoin de temps pour s’habituer aux stimuli de l’effort», explique David Schaad, physiothérapeute chez Medbase.
Ne pas tomber dans la monotonie
Offrez à votre corps différentes variantes de mouvement: faites du jogging sur différents terrains, faites des exercices de renforcement musculaire pour les jambes, le tronc et le haut du corps ou quelques exercices d’équilibre à la maison. Vous contribuerez ainsi à améliorer vos performances générales de course. «Pour une préparation optimale, il est important de solliciter l’ensemble du corps par différents moyens», explique le physiothérapeute.
Participez à notre concours et vous gagnerez peut-être des dossards gratuits pour la course de votre choix. Migros met en jeu 10 x 2 places de départ par course.
Pour participer: impuls.migros.ch/dossards
Prévoyez des pauses entre les séances d’entraînement pour la récupération. Cette dernière est nécessaire pour permettre au corps de s’adapter à l’effort et aux sollicitations de l’entraînement. Si les phases de récupération sont trop courtes, des symptômes de fatigue peuvent apparaître. La règle générale est la suivante: entre deux efforts intenses, il doit y avoir au moins un jour de repos ou un jour où vous ne faites qu’un entraînement alternatif léger.
Courir de longues distances nécessite non seulement de l’endurance, mais aussi de la puissance. Il est donc judicieux de pratiquer des exercices de renforcement musculaire pour les jambes, le haut du corps et le tronc. Des muscles entraînés augmentent la stabilité pendant la course et protègent des blessures. Un tronc musclé et solide vous permettra également d’aller plus vite en empêchant les mouvements d’évitement et de «gaspiller» moins d’énergie. MM

Migros, en tant que sponsor principal, et SportXX sont partenaires de nombreuses courses populaires dans toute la Suisse et permettent aux sportifs d’exercer leur passion dans les meilleures conditions. Les coureuses et les coureurs sont également récompensés pour leur participation par des programmes d’entraînement gratuits, des conseils de pro, des cadeaux et le clip personnalisé MyRun après la course.
Voici les plus grandes courses populaires soutenues par Migros en 2023:
18. 3. Course de Chiètres
29. 4. Course de la ville de Lucerne
29-30. 4. 20KM de Lausanne
6. 5. SOLA Stafette de Zurich
13. 5. Grand Prix de Berne
18. 5. Course de l’Ascension de Saint-Gall
3. 6. SOLA de Bâle
11. 6. Course féminine suisse à Berne
16. 9. Course du Greifensee à Uster
23-24. 9. StraLugano
1. 10. Course de Morat-Fribourg
14. 10. Course du Hallwilersee à Hallwil
2-3. 12. Course de l’Escalade à Genève
9. 12. Course de Noël de Sion
10. 12. Course de la Saint-Sylvestre de Zurich
subitoGo: scannez et payez avec l’app Migros.
Voici comment procéder:




1. Scannez et emballez vos achats
2. Payez avec l’app Migros



3. Terminé: vous évitez l’attente.

Christina Agapakis est directrice de création chez Ginkgo Bioworks, un pionnier de la biologie de synthèse basé à Boston (USA). Elle interviendra dans le cadre de la 19e Journée européenne des tendances à l’Institut Gottlieb Duttweiler (GDI) le 8 mars. Cette année, la conférence se concentrera sur le thème de la bioéconomie et sur la manière dont la compréhension de la nature et la relation avec celle-ci évoluent et où se trouvent les potentiels sociaux et entrepreneuriaux.
Informations: www.migmag.ch/ gdi-journee-tendances (en allemand et en anglais)
Pour la biologiste Christina Agapakis, son «fromage de pied» montre que nous sommes ce que nous mangeons.
La chercheuse américaine Christina Agapakis programme les bactéries et les cellules comme des ordinateurs. Le but? Nous aider à relever les défis en matière d’environnement et de santé.

Texte: Barbara Scherer
Christina Agapakis, vous avez fabriqué du fromage à partir de bactéries provenant des pieds. Cela n’a pas l’air très appétissant...
(Rires) Non, mais ce fromage n’est pas destiné à être mangé. Il s’agit plutôt de «nourriture pour le cerveau». Ce projet a vu le jour en 2010 et, à l’époque, il y avait encore beaucoup d’incompréhension vis-à-vis des micro-
organismes. Les bactéries étaient plutôt considérées comme une mauvaise chose, en particulier aux États-Unis. Je suis alors tombée sur ce que l’on appelle les bactéries propioniques, qui sont présentes aussi bien dans le fromage suisse que sur les pieds humains. Cela montre que nous sommes ce que nous mangeons. Mon «fromage de pied» ouvre une discussion sur notre
alimentation, notre corps et le rôle des bactéries dans notre vie.
Qu’avez-vous fabriqué d’autre?
Par exemple, dans le cadre d’un projet artistique, j’ai recréé le parfum d’une espèce d’hibiscus disparue originaire d’Hawaï.
Comment procédez-vous?
Nous traitons l’ADN comme un code que l’on peut programmer.
















Tout être vivant possède de l’ADN. C’est en quelque sorte son disque dur, sur lequel sont stockées toutes les informations héréditaires importantes. Nous recherchons des données spécifiques et les programmons. Pour ce projet, j’ai pris de l’ADN d’un hibiscus conservé, j’ai trouvé son parfum et je l’ai recréé.
Donc vous faites du génie génétique...
Oui. Cependant la biologie de synthèse se fonde sur une approche différente des précédentes: nous combinons la biologie et l’ingénierie. Nous voulons ainsi développer des outils permettant de programmer des cellules et des bactéries, avec lesquels il sera plus facile de travailler.
Quel rôle les bactéries programmées joueront-elles à l’avenir?
Elles peuvent par exemple être utilisées dans l’industrie de la parfumerie. En effet, dans ce domaine, nous avons besoin de plantes dont certaines sont menacées d’extinction. Des bactéries programmées peuvent remplacer durablement ces ingrédients et sauver ainsi des espèces végétales. Mais elles pourraient aussi un jour se substituer à tout ce que nous fabriquons à partir du pétrole.
Et qu’est-ce qui est déjà possible aujourd’hui?
En ce moment, nous travaillons sur les engrais. Des milliards de personnes peuvent être nourries grâce aux engrais azotés. Pourtant, la fabrication de ces derniers entraîne d’énormes dégâts environnementaux. Nous voulons programmer des bactéries afin qu’elles produisent de l’azote pour les plantes directement dans le sol, sans aucune pollution.
Les bactéries et les cellules programmées sont certainement aussi un sujet de discussion en médecine, non?
Oui, tout à fait. Les vaccins à ARN messager, comme le vaccin contre le coronavirus, sont basés sur cette technique. Le vaccin est
programmé pour se modifier dès que le virus mute. Il peut ainsi le combattre efficacement. Nous pourrions également programmer les globules blancs, qui constituent une grande partie de notre système immunitaire, afin de détruire de manière ciblée les cellules cancéreuses. Et les bactéries programmées pourraient aussi aider à la production de médicaments, par exemple en cas de rupture de stock.
Pourrait-on également programmer des bactéries pour qu’elles dévorent le plastique dans l’océan?
Pas exactement. Nous pourrons sans doute un jour programmer des bactéries pour qu’elles mangent du plastique. Mais si on les laissait dans l’eau, elles mourraient tout simplement. Et si elles devaient survivre, elles ne se développeraient probablement que très lentement et ne seraient pas en mesure de concurrencer les bactéries sauvages.
Devons-nous craindre les bactéries tueuses mutantes issues de laboratoires?
Non, la science n’est pas assez avancée pour cela. De plus, des mesures de sécurité strictes sont mises en place. Je dois dire que le plus grand risque avec les bactéries programmées, c’est qu’elles mutent pour revenir
à leur état d’origine et ne fassent plus ce pour quoi nous les avons modifiées.
Mais de telles bactéries pourraient servir d’armes biologiques...
En théorie, oui. Mais la Convention sur les armes biologiques, reconnue au niveau international, interdit l’utilisation ainsi que le développement, la fabrication ou le stockage d’armes biologiques. Il est sans doute plus important de dire que les virus et les bactéries se développent d’euxmêmes dans la nature et deviennent dangereux. C’est pourquoi il est important que la biotechnologie puisse également développer des outils permettant d’identifier les agents pathogènes dangereux et de réagir en cas de problème.
Comment?
Par exemple, en analysant l’ADN des eaux usées, on est à même de détecter les nouvelles
Le plus grand risque avec les bactéries programmées, c’est qu’elles mutent pour revenir à leur état d’origine.
variantes de virus, de surveiller l’apparition de la grippe aviaire dans un élevage ou encore de garantir le développement et la production rapides de nouveaux vaccins et traitements.
Malgré toutes ces possibilités, de nombreuses personnes se montrent critiques à l’égard du génie génétique...
C’est la raison pour laquelle je veux créer de merveilleux produits qui apportent des avantages aux gens. Mais, à mon avis, il est tout à fait raisonnable d’être sceptique et de poser des questions afin de comprendre ce qu’un nouveau produit est censé offrir. Je vois le génie génétique comme un outil qui peut nous aider à relever les défis en matière de santé et d’environnement.
La biologie deviendra-t-elle plus importante que la technologie à l’avenir? Tout dépend de ce que l’on entend par technologie! Je pense que la biologie est la chose la plus importante pour nous: après tout, la biologie, c’est notre vie. La manière dont nous développons cette discipline, cultivons nos aliments, interagissons avec notre environnement, traitons les maladies et fabriquons toutes sortes de produits, de matériaux et d’ingrédients, tout cela c’est déjà de la biologie. MM
«Nous pourrions programmer les globules blancs afin de détruire de manière ciblée les cellules cancéreuses»




Pour une bonne qualité de l’air ambiant, on recommande un taux d’humidité entre 30 et 50% dans les maisons et appartements. Un taux inférieur ou supérieur pourrait impacter la santé.
Comment conserver un taux d’humidité idéal dans sa maison?
L’Office fédéral de la santé publique (OFSP) préconise des mesures simples: pendant la cuisson, faire fonctionner la hotte aspirante. S’il n’y a pas de hotte aspirante, ouvrir les fenêtres. Dans la salle de bain, bien aérer après la douche ou le bain. Aérer tout l’appartement au moins trois fois par jour pendant 5 à 10 minutes en faisant des courants d’air. En hiver, l’aération permet d’évacuer une grande quantité d’humidité. Si l’air ambiant a tendance à être trop sec, il faut veiller à ne pas surchauffer les pièces (20-21 °C maximum). Après la douche, on peut en outre laisser sécher les serviettes de bain sur un étendoir dans l’habitation.
Les humidificateurs sont-ils utiles?
En principe, l’humidification n’est recommandée que si des problèmes de santé persistent malgré les mesures déjà mentionnées. À noter que ce n’est pas sur la base de ses sensations qu’il faut humidifier l’air, mais en augmentant de manière ciblée l’humidité à 40% et en la contrôlant régulièrement avec un hygromètre. Il convient en tout cas de s’assurer que murs et fenêtres ne soient pas humides. En effet, un air trop sec devient rapidement trop humide. Par ailleurs, il faut veiller à l’hygiène irréprochable de l’humidificateur: toujours utiliser de l’eau fraîche et nettoyer régulièrement l’appareil.
Si l’aération est régulière, l’utilisation d’appareils de déshumidification dans les pièces d’habitation ne devrait pas être nécessaire. Si l’humidité de l’air est trop élevée à long terme, signalez le défaut au propriétaire. Celui-ci doit faire examiner la cause de l’augmentation de l’humidité et y remédier. En cas de moisissures, n’utilisez en aucun cas des appareils de déshumidification, car les spores et les fragments de moisissures se répandent davantage dans l’air ambiant et peuvent par la suite entraîner des problèmes de santé.

Quelles conséquences si l’on descend en dessous d’un taux d’humidité de 30%?
Plus l’humidité de l’air est basse, plus les symptômes de dessèchement sont susceptibles de se manifester. Lorsque l’humidité de l’air ambiant est au-dessous de 30% pendant plusieurs jours, cela provoque l’assèchement de la peau et des muqueuses (yeux, nez et gorge). Les conséquences peuvent être des sensations de dessèchement et des irritations, des conjonctivites, de l’eczéma et un risque accru de refroidissement. Ces problèmes touchent tout particulièrement les personnes âgées. Cependant, toutes les personnes ne présentent pas de symptômes en cas de réduction de l’humidité de l’air.
Et si l’on dépasse un taux de 50%?
Un taux d’humidité élevé favorise la prolifération des acariens et des moisissures. Si des problèmes d’humidité et de moisissures se développent, des irritations des voies respiratoires, voire une toux chronique et de l’asthme, des irritations des muqueuses oculaires et de la peau peuvent apparaître. En outre, des réactions de stress telles que maux de tête, troubles du sommeil et fatigue peuvent survenir. MM
Plus de conseils?
Abonnez-vous à la newsletter.

Disponible chez:
m-budget-mobile.ch









Avoir une bonne hygiène intime protège contre les mauvaises odeurs et les infections.
Découvrez ce à quoi les femmes et les hommes doivent faire attention lors de leur toilette.
Texte: Petra Koci
À quelle fréquence l’hygiène intime est-elle nécessaire?
La règle est la suivante: moins, c’est mieux. Il suffit de rincer quotidiennement la zone intime à l’eau tiède. Il est également recommandé de se nettoyer avant et après les rapports sexuels.
Avec ou sans savon?
Les savons ou gels douche normaux sont trop alcalins pour cette zone sensible. Mais on peut utiliser une lotion lavante douce pour les parties intimes. Le mieux est d’opter pour un produit sans conservateurs et sans parfums, avec un pH adapté. Celui-ci ne doit être utilisé que pour la zone génitale externe – et cela vaut pour les deux sexes.
À quoi les hommes doivent-ils faire attention lors de leur toilette intime?
Les hommes doivent repousser doucement le prépuce lorsqu’ils se lavent et nettoyer la peau en dessous à l’eau tiède.
Le vagin se nettoie naturellement de lui-même grâce à ses bactéries lactiques. Les nettoyages vaginaux perturbent l’équilibre acide. Par ailleurs, contrairement à chez les hommes, l’urètre et l’anus des femmes sont proches l’un de l’autre. Le vagin n’est pas loin non plus. Par conséquent, le risque d’infection par des germes est plus élevé. Les femmes doivent donc penser à s’essuyer doucement de l’avant vers l’arrière quand elles vont aux toilettes. Sinon, des bactéries intestinales peuvent pénétrer dans le vagin et l’urètre et provoquer des cystites.
Quel rôle jouent les sous-vêtements dans l’hygiène intime?
Les sous-vêtements doivent être changés tous les jours. Les matières naturelles respirantes, comme le coton, sont recommandées. Dans le cas des culottes synthétiques pour femmes, une partie en coton au niveau de l’entrejambe peut suffire. Une culotte classique, pas trop serrée, est préférable à un string. Celui-ci peut frotter dans le sillon entre les fesses et pousser les bactéries intestinales au mauvais endroit.
Est-ce conseillé d’utiliser des lingettes humides?
Le sillon entre les fesses fait partie des endroits du corps qui transpirent. Il est également sensible, car la zone anale est le point de rencontre entre la peau et les muqueuses. Le mieux est de laver cette partie à l’eau tiède ou avec une lotion lavante douce. Certains utilisent des lingettes humides, mais celles-ci peuvent contenir des substances irritantes et poser un problème pour les égouts. L’idéal serait des toilettes avec jet d’eau intégré ou de se laver dans un bidet.

Est-ce bien de se raser les parties intimes?
Nos poils pubiens fonctionnent comme une climatisation: ils laissent passer l’air au niveau des zones intimes et empêchent la peau de devenir humide. Le fait qu’il serait plus hygiénique de se raser les parties intimes est donc un mythe. Pour les personnes qui préfèrent enlever leurs poils, l’épilation est possible mais peut être très douloureuse dans cette zone. La crème dépilatoire n’est pas appropriée, car elle ne doit jamais être en contact avec les muqueuses. Après le rasage – et en cas de peau sèche –, une lotion douce ou une crème de soin intime riche à base d’ingrédients naturels fera du bien. MM






























Participez et gagnez!
Question Combien de Bike World Camps existe-t-il?
Voici comment participer
• TÉLÉPHONE
0901 000 850 (Fr. 1.–/appel)
Indiquez la solution, votre nom et votre adresse
• SMS
Envoyez au numéro 3113 (Fr. 1.–/SMS) le message «MMFCHANCE», la solution, votre nom et votre adresse.
«Migros Magazine» met en jeu avec Bike World 5 places pour un Bike World Camp d’une valeur unitaire de 360 francs.

Organisés dans toute la Suisse, les 65 Bike World Camps de MS Sports proposent des programmes instructifs, intensifs et passionnants pour les enfants et les jeunes nés entre 2008 et 2017. Au cours de quatre journées variées, mêlant plaisir et action, les participants, encadrés par des cyclistes expérimentés, apprennent à rouler en toute sécurité et comment améliorer leur technique.


Composés de parcours d’obstacles et de petits tours sur des terrains
accidentés, les entraînements sont adaptés en fonction des capacités de chacun. Et passer d’agréables moments ensemble – p. ex. en jouant à des jeux de société après le repas de midi – fait également partie intégrante du programme, tout comme une alimentation adaptée.
Certains Bike World Camps peuvent aussi être réservés avec hébergement et encadrement 24 heures sur 24 Plus d’informations sur: bikeworld.ch/ bikeworldcamps MM
Exemple: MMFCHANCE, solution, Jean Exemple, Rue exemple 1, 9999
Exempleville
• EN LIGNE
www.migmag.ch/ concours
Participation gratuite prise en compte de manière équivalente
Date limite: 12 mars 2023
Conditions de participation: www.migmag.ch/ conditionsparticipation
3 nuitées avec demi-pension
Entrées journalières au bain thermal de Loèche-les-Bains y compris sauna et bain vapeur, accès libre au téléferique de la Gemmi, Leukerbad plus Card. Fr. 415.- par personne
5 nuitées avec demi-pension
Entrées journalières au bain thermal de Loèche-les-Bains y compris sauna et bain vapeur, accès libre au téléferique de la Gemmi, Leukerbad plus Card. Fr. 685.- par personne
7 nuitées avec demi-pension
Entrées journalières au bain thermal de Loèche-les-Bains y compris sauna et bain vapeur, accès libre au téléferique de la Gemmi, Leukerbad plus Card. Fr. 931.- par personne
Supplément pour la chambre individuelle Fr. 10.– par jour sur tous les arrangements.


La plus grande piscine thermale alpine de l‘Europe (Leukerbad Therme) est à votre disposition le jour d‘arrivée dès 12h 00.

T 027 472 70 70 info@alpenblick-leukerbad.ch alpenblick-leukerbad.ch
Offres spéciales bains 2023 20x 20x



Résolvez les mots fléchés et gagnez l’un des 2 bons d’achat Migros d’une valeur de 100 francs chacun. Pour la case verte, gagnez l’une des 2 cartes cadeaux Migros d’une valeur de 50 francs chacune!

Comment participer
Prix principal (mot en orange):
Tél.: 0901 000 861 (Fr. 1.–/appel)
SMS: envoyez MMF1 suivi de la solution, vos nom et adresse au 3113 (Fr. 1.–/SMS)
Exemple: MMF1 BARBIER Hugo Lexemple, Rue Lexemple 44, 1200 Modèleville
Internet: migrosmagazine.ch/mots-fleches (gratuit)
Gagnants «en plus» (mot en vert):
Tél.: 0901 000 865 (Fr. 1.–/appel)
SMS: envoyez MMF5 suivi de la solution, vos nom et adresse au 3113 (Fr. 1.–/SMS)
Exemple: MMF5 HIVER Hugo Lexemple, Rue Lexemple 44, 1200 Modèleville
Internet: migrosmagazine.ch/mots-fleches (gratuit)
Délai de participation:
Gagnants n°
Prix principal:
dimanche 12.3.2023, à minuit
Marie-Claude Gilliard, Neuchâtel et Trudi Braun, Sirnach TG
Gagnants «en plus»:
Josette Frutiger, Le Locle NE et Peter Werder, Allschwil BL
Conditions de participation:
Sont autorisées à participer toutes les personnes domiciliées légalement en Suisse ou dans la Principauté du Liechtenstein et âgées de 18 ans révolus. Les collaborateurs de l’organisatrice du concours, ainsi que les associations de jeux-concours, les services automatisés et les autres services de participation professionnels et commerciaux ne sont pas autorisés à concourir. Les gagnants seront informés par e-mail, et leurs noms et localités seront publiés.
Comment participer
Téléphone: 0901 000 864 (Fr. 1.–/appel)
2 × 100 francs à gagner

Remplissez les cases vides avec les chiffres 1 à 9. Chaque chiffre ne peut apparaître qu’une seule fois dans chaque rangée, chaque colonne et chacun des neuf blocs 3×3. La solution s’affiche dans les cases orange, de gauche à droite.
SMS: envoyez MMF4 suivi de la solution, vos nom et adresse au 3113 (Fr. 1.–/SMS)
Exemple: MMF4 456 Hugo Lexemple, Rue Lexemple 44, 1200 Modèleville
Internet: www.migrosmagazine.ch/sudoku (gratuit)
Délai de participation:
dimanche 12.3.2023, à minuit
Que vais-je cuisiner aujourd’hui? migusto.ch


De jeudi à dimanche uniquement
50% à partir de 2 articles










Tout l’assortiment Nivea (excepté les formats de voyage, les coffrets cadeaux et les emballages multiples), par ex. Crème de Jour Anti-Rides Q10 Power FPS 15, 50 ml, 7.- au lieu de 13.95












2 × 100 francs à gagner
Répondez aux questions du quiz. En reportant les lettres correspondant aux bonnes réponses dans la grille de solution, vous trouverez le mot code.
Selon l’expression, quel insecte peut-on entendre voler dans un profond silence?
M P H Une coccinelle Une mouche Une abeille
Qu’est-ce qu’un sonnet?
E I A Un animal Une arme blanche Une forme de poème
Quel est l’ingrédient principal de la tartiflette au reblochon?
R N S Concombres Betteraves Pommes de terre
Dans quel canton est situé le lac Grenon?
S O E Valais Berne Genève
Le «claymation» est une animation de … utilisée dans des films en image par image.
A I D pâte à modeler carton tissu
Le monastère Saint-Jean-Baptiste est une abbaye … située à Müstair.
O R U bénédictine capucine dominicaine
Ludwik Fleck était un médecin et biologiste spécialiste …
D T N des oreillons de la rougeole du typhus
2 × 100 francs à gagner
Remplissez la grille avec les dix mots. Chaque case de 1 à 5 correspond à une lettre de la solution.
Comment participer
Téléphone: 0901 000 862 (Fr. 1.–/appel)
SMS: envoyez MMF2 suivi de la solution, vos nom et adresse au 3113 (Fr. 1.–/SMS)
Exemple: MMF2 HIBOU Hugo Lexemple, Rue Lexemple 44, 1200 Modèleville
Internet: www.migrosmagazine.ch/quiz (gratuit)
Délai de participation:
dimanche 12.3.2023, à minuit
Conditions de participation: sur la première page de jeux
Comment participer
Téléphone: 0901 000 863 (Fr. 1.–/appel)
SMS: envoyez MMF3 suivi de la solution, vos nom et adresse au 3113 (Fr. 1.–/SMS)
Exemple: MMF3 ORAGE Hugo Lexemple, Rue Lexemple 44, 1200 Modèleville
Internet: www.migrosmagazine.ch/paroli (gratuit)
Délai de participation:
dimanche 12.3.2023, à minuit
Conditions de participation: sur la première page de jeux
Le chiffre à côté de chaque colonne et de chaque ligne indique le nombre de cases occupées par les navires. Ils ne peuvent pas se toucher et doivent être complètement entourés par l’eau, sauf s’ils touchent le bord.
solution n° Bimaru solution n° 9 9
Sudoku solution n° 9
Sudoku gagnants n°
solution n° 9
gagnants n° 8 Paroli gagnants n° 8 8
Marianne Duvoisin, Yverdon-les-Bains VD; Albert Malär, Uitikon Waldegg ZH
Sylviane Clerc, Fully VS; Eveline Lanz, Liebefeld BE
Denise Sonney, Semsales FR; Brigitte Meier-Jenni, Liestal
1 On a en tête l’image d’Épinal du détective privé qui planque seul dans sa voiture pendant des heures. Réalité ou fiction? Franchement, ce n’est pas si éloigné que ça de la vérité. Notre métier est effectivement fait de longs moments de surveillance et de filatures. Mais nous travaillons surtout en binôme.
Bio express Administratrice de la société Sabrina Bénézet SA, la quadragénaire est arrivée dans le métier après des études de droit. Son mari, lui-même professionnel de la branche, lui en a transmis la passion. Depuis les années 2000, elle a développé son activité en Suisse et en Europe et compte désormais une dizaine de collaborateurs.
Texte: Thomas Piffaretti2 Que faites-vous pendant les longs moments de surveillance? Des sudokus? Non, pas du tout. On doit rester tout le temps concentré, être prêt à partir à n’importe quel moment si notre objectif bouge. Parfois le dispositif peut être déployé sur plusieurs jours, c’est pour ça qu’on a toujours un sac dans le coffre avec le nécessaire pour passer une nuit loin de chez nous. C’est tout un art, un jeu entre deux ou trois fileurs et la cible.

3 Qui sont vos cibles? On couvre des activités très différentes. Ça va de l’époux ou de l’épouse qui soupçonne son conjoint d’entretenir une
relation extraconjugale au patron convaincu que son employé exerce une activité annexe ou transmet des informations à la concurrence. Notre mission est de produire des preuves irréfutables à notre client qui pourra les utiliser, notamment dans le cadre d’une procédure judiciaire.
4 Y a-t-il des particularismes dans les demandes en fonction des régions?
À Genève, on fait passablement de criminalité économique. Du côté de Fribourg, on a plusieurs cas d’employeurs qui veulent s’assurer de la bonne foi d’un
Sabrina Bénézet prend en filature des conjoints volages ou traque des employés qui revendent les secrets de leur patron.
Depuis vingt-deux ans, elle mène l’enquête en Suisse comme à l’étranger.
Le cœur du métier de détective reste la filature, pure et dure.
salarié en arrêt maladie ou accident. Ça arrive qu’on les observe courir sans leur minerve. Pour les adultères, il n’y a pas de spécialité régionale, il y en a partout. Et c’est 50-50 entre hommes et femmes.
5 Comment cela se passe-t-il lorsque vous annoncez à un client qu’il est trompé? Il y a une vraie dimension psychologique à notre métier. Certains me disent qu’ils soupçonnent leur conjoint d’avoir une aventure depuis plus d’un an et que ça les ronge de l’intérieur. Ils ne pensent pas immédiatement à nous, mais on est vraiment là pour aider les gens, les soutenir et soulager leur peine.
6 Les nouvelles technologies ont-elles chamboulé vos méthodes?
On est équipés de téléobjectifs qui permettent de prendre une
photo à 800 mètres de distance. On a des caméras infrarouges ou avec vision nocturne et on possède aussi le matériel qui permet de nous assurer qu’un micro – grand comme une tête d’épingle – n’est pas caché au milieu des bouteilles d’eau d’une salle où une réunion sensible va se tenir. Mais sinon, on pratique à l’ancienne. Le cœur de notre métier reste la filature, pure et dure. Nous faisons très attention aux atteintes à la vie privée. On se doit de respecter la loi. Par exemple, si on veut des preuves d’un adultère, on ne pourra pas prendre de photos de deux amoureux qui s’embrassent lorsqu’on les voit à travers une fenêtre. Par contre, s’ils passent à l’action sur un balcon, nous pouvons les immortaliser selon le contexte. C’est aussi la raison pour laquelle on ne fouille pas dans les discussions WhatsApp.
7 Les personnes surveillées se rendent-elles compte de votre présence?

Ça n’arrive pas. Et avec l’expérience, on sait improviser dans les situations un peu chaudes. C’est aussi pour éviter ces cas de figure qu’on emporte toujours deux ou trois tenues différentes pour se changer et mieux se fondre dans le paysage.
8 Détective privé, c’est une activité dangereuse?
Disons qu’il faut toujours avoir un œil dans le rétroviseur, analyser, anticiper. Certains privés possèdent un permis de port d’arme. Personnellement, je n’ai jamais eu de problème. Ça fait partie de l’adrénaline de partir en mission. C’est surtout un métier usant, dans lequel on est toujours dehors, avec des horaires impossibles. MM
9 Être une femme dans un univers a priori masculin, est-ce un avantage?
C’est très clairement un plus! J’ai d’ailleurs plusieurs collaboratrices dans mes équipes. Une femme passe plus facilement inaperçue. Les gens s’attendent à voir quelqu’un avec une tête de détective, avec une coupe en brosse et un look de militaire. Ils se méfient moins d’une femme.
«C’est surtout un métier usant, dans lequel on est toujours dehors, avec des horaires impossibles»
24.95 Vase en verre 13,5 cm x 22 cm, disponible en vert, taupe ou transparent, la pièce






7.95
Les articles bénéficiant déjà d’une réduction sont exclus de toutes les offres. Offres valables du 7.3 au 13.3.2023 ou jusqu’à épuisement du stock.



7.95 Bougeoir en céramique disponible en vert, crème ou brun, Ø 12 cm, la pièce
Lapins en bois à poser 18 cm, disponibles en blanc, marron et vert, la pièce
7.95 Bol disponible en beige, Ø 15 cm, la pièce